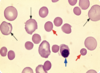
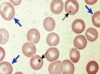
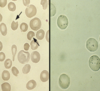
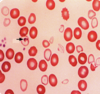
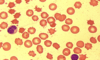
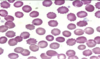
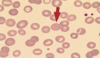
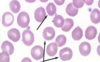

¿Dónde empieza la hematopoyesis?
¿En qué semanas?
Saco vitelino
Primeras 6
¿Quién sustituye al saco vitelino en semanas 6-8?
¿A partir de cuándo disminuye?
Hígado
6° mes
Principal sitio de hematopoyesis en el 6° mes
MO
Huesos que hacen hematopoyesis en la infancia
Todo el esqueleto
Huesos que hacen hematopoyesis en un adulto
- Vértebras
- Esternón
- Costillas
- Pelvis
- Cráneo
- Epífisis prox de fémur y tibia
¿Qué se origina del mesodermo?
Cel. mesenquimatosas que se diferencían en cel. y vasos sanguíneos
Funciones de la EPO
¿A qué tipo de receptor se une?
- Hematopoyética
- Angiogénica
- Antiapoptótica
JAK-STAT → SH2 domain → dimerización
Metabolismo del eritrocito
- Glucólisis anaeróbica (glucolítica o de Embden-Meyerhof)
- Pentosas
¿Qué efecto es?
A un pH menor la hb se unirá al O2 con menos afinidad
Efecto Bohr

¿Qué efecto es?
Desoxigenación de la 🩸 incrementa la habilidad de la hb para portar CO2
Efecto Haldane

Partes del hueso
- Cortical/compacto
- Esponjoso/trabecular

Partes del hueso esponjoso
- Médula roja
- Médula amarilla
¿Qué hay en entre trabécula y trabécula?
MO
Precursores
Compartimentos de la MO
- Hematopoyético
- Vascular
¿Qué contiene el compartimento hematopoyetico de la MO?
- Parénquima
- Estroma
¿Qué contiene el compartimento hematopoyetico (parénquima) de la MO?
- Megacariocitos en paredes de sinusoides
- Islotes eritroblásticos: MQ rodeado de eritroblastos
- Granulocitos
¿Qué contiene el compartimento hematopoyetico (estroma) de la MO?
- Cel reticulares: MQ, adipocitos
- MEC: fibras reticulares, proteog. y gp de adhesión (laminina y fibronectina)
Células madre
Pueden crecer y formar un organismo completo
Ej: cigoto
Totipotentes
Células madre
No pueden formar un organismo completo, pero sí células de endo-, ecto- o meso-
Ej: células madre embrionarias
Pluripotentes
Células madre
Pueden generar células de su mismo linaje embrionario
Ej. Células madre hematopoyéticas
Multipotentes
Células madre
Células progenitoras
Ej. Células madre musculares
Unipotentes
¿Quiénes regulan el microambiente de la MO?
Citocinas estimuladoras e inhibitorias
Microambiente de MO
¿Qué hace la proteína morfogénica ósea 4 (BMP-4)?
Induce a cel. primitivas convertirse en CPH
Microambiente de MO
¿Qué hace la proteína tipo angiopoyetina (AngPtl)?
Regula estado quiescente en CPH